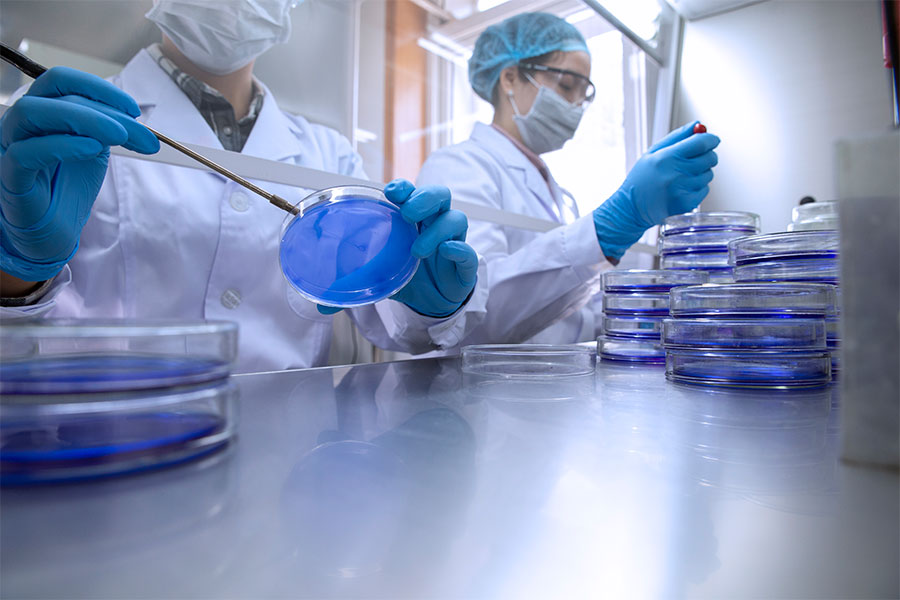

中國國檢測試控股集團股份有限公司(股票簡稱“國檢集團”,英文簡稱CTC,股票代碼603060)起源于20世紀50年代中國建材總院檢驗認證業務板塊,經過70載不懈努力與執著追求,形成檢驗檢測、認證評價、檢測儀器及智能制造、計量校準、科研及技術服務五大業務平臺,致力于為客戶提供質量、環保、綠色、安全、健康、節能等領域的檢驗檢測、認證評價、鑒定、咨詢、培訓、儀器裝備等技術服務及綜合性解決方案。
國檢集團總部位于北京,在全國22個省、市、自治區設有59余個法人機構、34個國家級行業產品質檢中心,5900余名優秀員工,服務能力覆蓋建筑材料與建設工程、環境、智能制造、軌道交通、醫學健康、食品及農產品、化妝品及日化用品、地質礦產等行業的設計、研發、生產、使用、物流、消費各個環節。
國檢集團堅持創新發展,近年來累計完成與在研省部級以上科研項目200余項;主持發布與在研ISO、IEC國際標準16項,國家、行業、地方標準700余項,獲授知識產權1800余項;積極踐行央企責任與擔當,成為奧運工程、上合峰會、APEC會議、金磚會議等國家重點工程唯一環境質量控制服務商;服務國家“雙碳”目標,為全國20 多個省市,近3000 家企業提供技術服務。
未來,國檢集團將秉承“公正為本、服務社會”的核心理念,以建設世界一流綜合型檢驗認證機構、打造檢測認證服務的“中國品牌”為目標,持續推動高質量發展,為“質量興國”、建設美好生活貢獻國檢力量!
中國國檢測試控股集團股份有限公司(股票簡稱“國檢集團”,英文簡稱CTC,股票代碼603060)起源于20世紀50年代中國建材總院檢驗認證業務板塊,經過70載不懈努力與執著追求,形成檢驗檢測、認證評價、檢測儀器及智能制造、計量校準、科研及技術服務五大業務平臺,致力于為客戶提供質量、環保、綠色、安全、健康、節能等領域的檢驗檢測、認證評價、鑒定、咨詢、培訓、儀器裝備等技術服務及綜合性解決方案。
國檢集團鄭重承諾:企業將客觀、科學、規范地遵守相關法律法規和質量標準要求,建立健全質量管理體系、完善質量檔案,積極履行社會責任、重視質量發展、大力開展質量提升行動,切實做好關鍵過程質量控制、質量檢驗和計量檢測、健全產品質量追溯體系等工作,持續著力提升質量水平,全力承擔保障質量安全、履行質量擔保責任及缺陷產品召回等法定義務的質量主體責任,適時以相關方式對企業的產品和服務標準進行必要的自我聲明,依法承擔質量損害賠償責任,遵守市場秩序,維護公平競爭,切實維護消費者合法權益。
服務范圍:檢驗檢測、認證評價、檢測儀器及智能制造、計量校準、科研及技術服務
服務電話:4000100010

京公網安備 11010502043458號